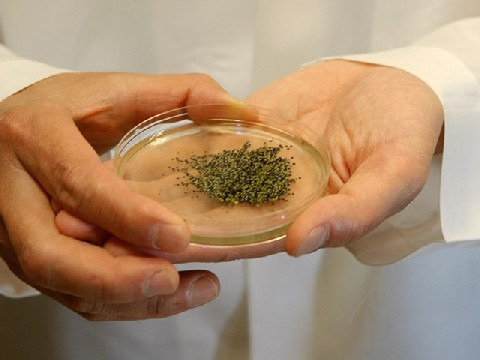
Vị của trứng muỗi được người ta mô tả là ngọt ngọt, cay cay, hơi chua chua chứ không béo ngậy như trứng kiến. Ảnh: googleusercontent.

Trang Pháp - Băng Di không chỉ là đồng nghiệp mà còn là những người bạn thân thiết trong cuộc sống. Tình bạn 13 năm của cả hai khiến nhiều người ngưỡng mộ.




Các hình khắc cổ đại dài tới 40 mét, mô tả rắn, người và rết, được coi là bộ sưu tập lớn nhất từng ghi nhận về nghệ thuật tiền sử.

Trang Pháp - Băng Di không chỉ là đồng nghiệp mà còn là những người bạn thân thiết trong cuộc sống. Tình bạn 13 năm của cả hai khiến nhiều người ngưỡng mộ.

Giữa khung cảnh tuyết trắng xóa, hình ảnh một cô gái trong bộ trang phục 'Supergirl' đầy quyền năng nhưng không kém phần quyến rũ đang trở thành tâm điểm chú ý.

Theo tử vi 12 cung hoàng đạo ngày 17/1, Bọ Cạp hanh thông mọi chuyện, tâm tình thư thái. Cự Giải chú ý làm việc dứt khoát hơn, đừng lề mề.

Với giá hơn 100.000 đồng/bó, dăm đào bạch sắc trắng tinh khiết đang được không ít người tiêu dùng lựa chọn về chơi Tết sớm.

Toyota Land Cruiser 300 HEV 2026 – phiên bản hybrid của dòng xe SUV hạng sang đầu bảng đang tiến gần hơn đến thời điểm ra mắt tại thị trường Đông Nam Á.

Không gian sống của Phi Thanh Vân thiết kế theo phong cách hiện đại, tối giản, sử dụng sắc trắng chủ đạo.

Không chỉ Tuấn Ngọc, nhiều sao Việt cũng chia tay người bạn đời sau hàng thập kỷ về chung một nhà.

Phi công lái F-16 của Ukraine đã cố gắng hết sức, nhưng vẫn không thể né tránh đòn tấn công của hai tên lửa phòng không S-300 của Nga.

Trở lại đường đua thời trang sau thời gian sau sinh em bé, Ly Phạm vẫn khiến người hâm mộ xuýt xoa với màn lên đồ cực 'slay'.

Trong 2 tháng đầu năm, 4 con giáp này gặp nhiều may mắn về tiền bạc, sự nghiệp, và cơ hội làm giàu rực rỡ, đón Tết sung túc.

Vallum Antonini là công trình phòng thủ ít được biết đến, phản ánh tham vọng và giới hạn quyền lực của Đế chế La Mã ở cực Bắc châu Âu.

Peugeot vừa ra mắt phiên bản nâng cấp giữa vòng đời cho mẫu 408 tại châu Âu. Phiên bản 2026 đánh dấu những thay đổi toàn diện về thiết kế lẫn truyền động.

Đình làng Đình Bảng (Bắc Ninh) là một trong những công trình đình cổ tiêu biểu nhất vùng Kinh Bắc, lưu giữ nhiều giá trị lịch sử và nghệ thuật đặc sắc.

Các loài loài công (chi Pavo) từ lâu đã gắn liền với vẻ đẹp vương giả, quyền lực và nhiều lớp ý nghĩa văn hóa sâu sắc.

Giữa cơn bão giá RAM và GPU rời leo thang, Intel tin rằng đồ họa tích hợp đang bước vào thời kỳ “chiến thắng” nhờ tích hợp, AI và chi phí tối ưu.

Không chọn nghỉ ngơi ở tuổi 69, cô Lan lặng lẽ băng rừng, vượt dốc, chinh phục hai đỉnh núi Tây Bắc trong hai tháng, khiến người trẻ cũng phải nể phục.

Sau khi được xướng tên tại Cánh Diều Vàng 2025, Thu Trang, Tuấn Trần, Hồng Đào, Ngọc Huyền, Phương Nam đã có chia sẻ về giải thưởng, chặng đường làm nghề.

Mẫu xe môtô Verge TS Pro chạy điện ra mắt với pin thể rắn không chỉ giúp đưa tới quãng đường vận hành ấn tượng, mà còn cho tốc độ sạc nhanh kỷ lục.

Ở tuổi ngoài 40, Hiền Thục khiến khán giả ngỡ ngàng bởi vẻ ngoài tươi trẻ. Loạt ảnh đời thường được cô chia sẻ tiếp tục chứng minh nhan sắc “hack tuổi”.